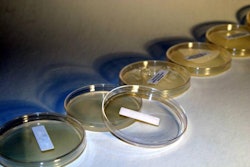

Farm, restaurant and grocer associations were opposed to Assembly Bill 2959
A California proposal that would have changed the way many livestock producers in the state obtain food byproducts for use as animal feed has been shelved.
Assembly Bill 2959 has been opposed by California farm groups, along with restaurant and grocer associations. The California Farm Bureau, California Cattlemen’s Association, Western United Dairies, California Restaurant Association, California Grocers Association and California Retailers Association have said they would work together to defeat the bill. The Association of California Egg Farmers, California Grain and Feed Association, biomass-based biodiesel producers and other associations and small business owners have also said they oppose the bill, which they say would change regulations and add costs to 1.8 million businesses.
The bill was introduced in February by Assemblymember Ian Calderon (D-Whittier), cleared the Assembly in June and was scheduled to be heard this week in the Senate Environmental Quality Committee, but was shelved on August 11.
Under the bill, livestock producers would no longer have been able to receive food byproducts from retail and commercial establishments, including grocers, restaurants and others, if the local jurisdiction has a contract with a franchise waste hauler, according to the California Farm Bureau Federation.
“We are pleased to see that restrictions on livestock feed, through AB 2959, will no longer be pursued this year,” said Taylor Roschen, policy advocate for the California Farm Bureau Federation. “As California works toward managing its organic waste, our farms, dairies and ranches upcycle these products to put better, safer, healthier food on our tables. We look forward to continuing to highlight that invaluable service.”
The California Grain and Feed Association said it would continue its initiatives to educate others about food waste for animal feed.
“The California Grain and Feed Association, working closely with the California Farm Bureau Federation, California Grocers Association and California Restaurant Association led a broad coalition of entities that recycle organic material for feed, biofuels and industrial uses to defeat the measure,” the group said in an update to its members. “We have much more work to do continuing to educate legislators and local government entities of the importance of food waste and other organic materials for feed and other uses and we will continue this education process throughout the year.”
Bill would have updated previous law
The California Integrated Waste Management Act of 1989, administered by the Department of Resources Recycling and Recovery, regulates the disposal, management and recycling of solid waste. It prohibits local governmental entities from exercising their authority with regard to the hauling of byproducts from the processing of food or beverages if certain conditions are met, including the condition that the byproducts originate from, among others, entities required to be registered for the manufacture, packing, or holding of any processed food in the state and certain entities exempt from that registration.
Assembly Bill 2959 aimed to reauthorize those local governmental entities to exercise their authority if those byproducts originate from a retail or commercial establishment such as a supermarket, grocer, restaurant, or other retail food establishment. The bill would additionally prohibit those local governmental entities from exercising that authority if those byproducts originate from a winegrower or brandy manufacturer, as defined, under those same conditions, and would make other specified revisions to these provisions.